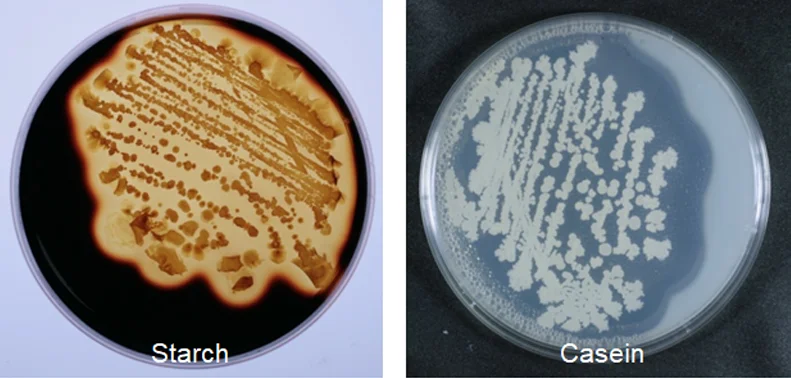

DCPA Dicalcium Phosphate Anhydrous For Animal Feed/Mono Dicalcium Phosphate
US $200.00-$400.00
Share on (11000000093312):

Product Name | ARIAKE1 |
Brand Name | BioJan |
Place Of Origin | Japan |

Quantity(Kilogram) | 1-1,000 | 1,001-5,000 | >5,000 | ||
Est. time (days) | 21 | 35 | To be negotiated | ||



New products from manufacturers at wholesale prices